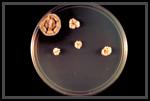

Drug Use Education.org
| RECENT ADDITIONS ON THIS WEBSITE |
|
DEA Controlled Substances List
DUE: No "Bad" Choices Left Behind History: Inside Nixon's Doll House
History: US Prohibition (1920-33)
|
| DEFINITIONS ON THIS WEBSITE |
|
Use |
|
|
|
|
||
|
DUE is the presentation of an entire societal transformation
|
||
|
Using Alcohol & Drugs is NOT a Sport; It Must Have A Calculated Medical Value |
||
| Children with chronic disorders that require learning about drug use are less likely to use illicit drugs; those who do rarely wind up in a hospital ED. This carries through to adulthood. The primary reason for drug abuse is lack of education. It's impractical that everyone is going to |  STEP
1: Preparation for drug
use education is learning good hygiene. STEP
1: Preparation for drug
use education is learning good hygiene.
STEP 2: Nutrition is an important part of healthcare. The body needs fuel to process chemicals. It is dangerous to use stimulants that reduce the desire to eat. Damage to the brain and other organs can result from lack of food |
|
 STEP
3: The
most important step of the drug use process is learning how to calculate
doses correctly and accurately. Many young people think that if they
don't "feel" the effect of something, they need to increase the
dose. This is the way abuse begins. If you don't feel
something right away, it's because the metabolism is slow to react.
DON'T OVERDOSE. STEP
3: The
most important step of the drug use process is learning how to calculate
doses correctly and accurately. Many young people think that if they
don't "feel" the effect of something, they need to increase the
dose. This is the way abuse begins. If you don't feel
something right away, it's because the metabolism is slow to react.
DON'T OVERDOSE. |
 |
|
| Today, engaging in intravenous drug use can mean a sterility problem with makeshift hardware and devices that are prone to produce infections such as "cotton fever" and other less pleasant experiences. Drug Use Education discourages such hardware and shows how infections can be avoided. |
|
Healthcare in the US is far more deficient today than ever before. DUE will be useful in training youth and guiding them to careers in nursing and healthcare. |
 |
Clinical research, phlebotomy, CPR, and other useful healthcare techniques will serve as the foundation of DUE. Students will also be taught the basics of pharmacology, classes of medication, and what to do in emergency situations. In a sense, DUE is like classwork toward an RN or LVN degree. |  |
| DUE is healthcare education. Our vision of the future is the progression of healthcare allowing the patient to exercise greater responsibility over his or her health. This includes self-diagnosis based on testing. |
|
By taking over the tasks and functions performed in the provider's office, the patient's healthcare costs will decline and the patient will be able to better understand his or her body |
 |
Students who know something about drugs always have an advantage over those who don't. Reason? Knowledge is power. The premise of DUE is to take away ignorance so that controlled substances can be avoided. Today, there are a number of physicians who couldn't tell you what a white cross is, or what treatment to use for certain disorcers. |  |
| DUE is about ordinary students becoming the brains of tomorrow's world. It forces hospitals and healthcare centers to improve their quality by becoming educational institutions within the community. |
|
DUE allows an educational transformation by offering students courses that have value for everyday living. |
|
The actual curriculum of DUE is still to be debated. But one thing is certain: Drug Abuse Education we teach today is not going stop drug abuse. We can't expect teaching the wrong way or no way at all is going to accomplish anything. If we teach a kid the wrong way to swim, the kid is just going to learn the wrong way to swim. He or she isn't going to learn the right way by learning the wrong way. |  |
 |
||



